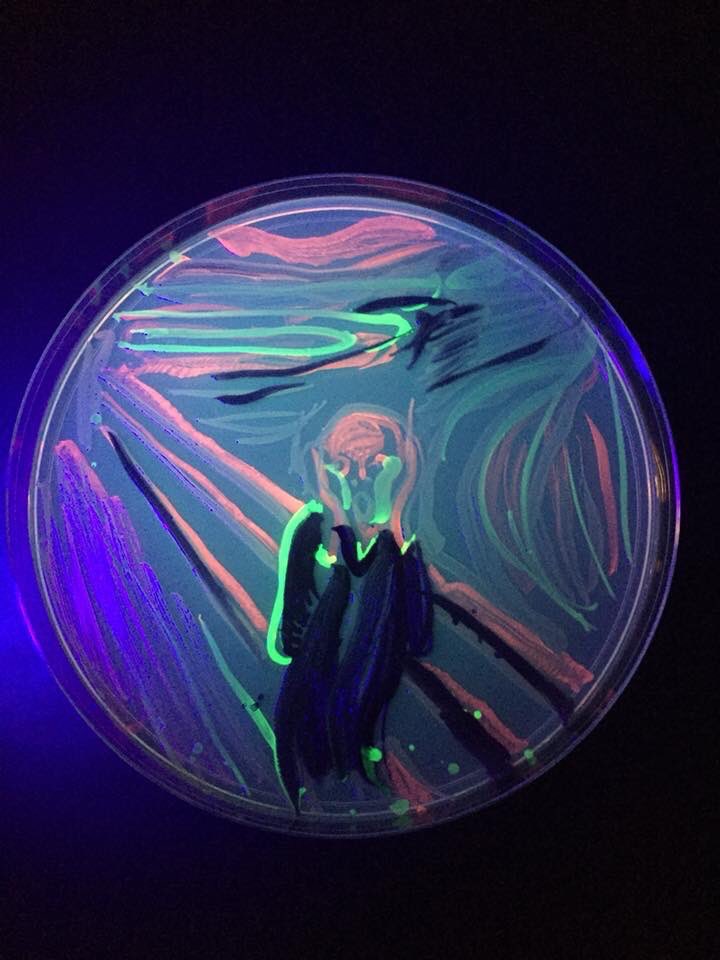
Two years ago, my wife Jennifer Quinn painted this lovely bit of #AgarArt using GFP and RFP and violacein expressing E. coli. Please applaud her! <a href="/univpugetsound/">Univ. of Puget Sound</a> <a href="/ASMicrobiology/">ASM</a> <a href="/swirlgirl31415/">Jennifer Quinn</a>
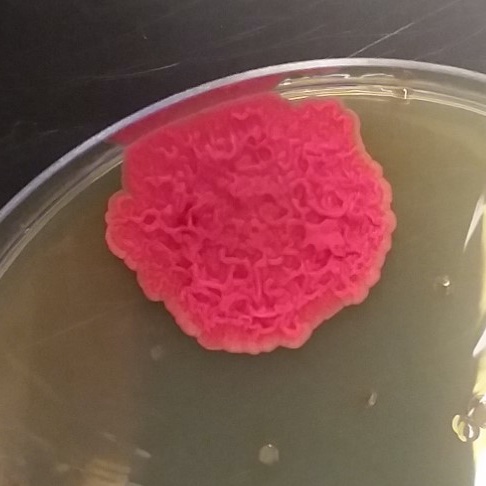
<a href="/Social_Biofilms/">The Social Biofilm Network</a> Here's a fun contaminant/lab pet unearthed from the 4C during our last lab cleanup day! <a href="/ContamClub/">Contamination Club</a>

Petri Dish Picasso
@petripicasso
Canadian Student Organization Showcasing the Breadth and Beauty of Microbiology Through Agar Art 🔬🎨 🇨🇦
ID: 759183809258545157
http://Instagram.com/PetriDishPicasso 30-07-2016 00:28:19
620 Tweet
1,1K Followers
74 Following

More #violacein-producing #bacteria getting #weird in Jonathan Eisen lab. Duganella violace....?

Two years ago, my wife Jennifer Quinn painted this lovely bit of #AgarArt using GFP and RFP and violacein expressing E. coli. Please applaud her! Univ. of Puget Sound ASM Jennifer Quinn

⏰2 years ago I painted 🎨#TheStarryNight ✨🌙 of #VanGogh in a #PetriDish 🧫 using #bioluminiscent #bacteria isolated from a squid 🦑during the #microbiology 🦠practices in Facultad de Ciencias 🔬 Universidad de Navarra #AgarArt #bioart #unav #ArtScience #SciArt #art #science FECYT



The Social Biofilm Network Here's a fun contaminant/lab pet unearthed from the 4C during our last lab cleanup day! Contamination Club

🧫Vibrant Symbiosis: Achieving reciprocal #ScienceOutreach through #BiologicalArt —Super cool #SymbioticOutreach model + vital #DiversifyArtScience work —bit.ly/2Pd2pVE PLOS Biology by Lindsey Lopes et al. #SciComm #ArtScience #Streptomyces #BioArt











